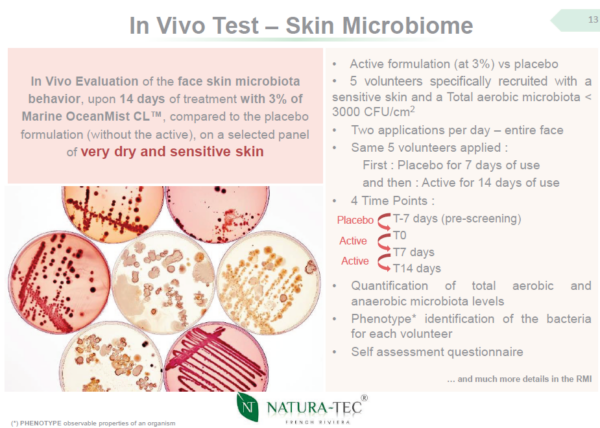

Executive Summary
Clean skincare for sensitive skin needs more than basic moisturization. As a marine-derived, microbiome-conscious active, Marine OceanMist CL™ supports a better approach to barrier repair by helping reinforce skin’s structural defenses, improve comfort in dry, reactive skin, and fit streamlined formulation strategies. For brands and R&D teams building modern barrier-first products, it offers a practical route to clean-label positioning with benefits tied to barrier support, skin tolerance, and everyday formulation versatility.
Barrier repair is no longer a secondary benefit in clean skincare — it is the performance standard that determines whether “gentle” products truly work.
Consumers are choosing products labeled clean, minimalist, and skin-friendly in record numbers. Yet many of these formulas rely on basic moisturization strategies that soften skin temporarily without improving its structural resilience. For sensitive and reactive skin types, that gap between appearance and biological performance is where product dissatisfaction begins.
Recent industry coverage has highlighted a clear shift toward ingredient-aware purchasing behavior. Shoppers increasingly seek recognizable ingredients, dermatologist-aligned positioning, and credible efficacy signals rather than broad “free-from” messaging alone. This evolution changes formulation priorities. Products must be mild in composition while being effective in skin function support — especially for barrier integrity and tolerance.
For cosmetic formulators and product development teams, this is not a marketing nuance. It is a structural design challenge requiring ingredients that reinforce the stratum corneum, maintain microbiome balance, and improve resilience without increasing irritation risk or complicating INCI lists.
Why Barrier Repair Has Become Central to Sensitive Skin Formulation
The skin barrier functions as a protective interface between the body and the environment. When intact, it regulates water balance, prevents irritant penetration, and supports microbial equilibrium. When compromised, water loss increases, inflammatory responses intensify, and skin becomes more reactive to environmental stressors and formulation components.
Traditional sensitive-skin formulations often rely heavily on occlusives and humectants. These ingredients reduce surface dryness and temporarily improve feel, but they do not necessarily strengthen the structural components responsible for long-term barrier resilience.
True barrier support requires restoring the organization of lipids and proteins within the outermost skin layer. Without structural reinforcement, hydration gains are short-lived and sensitivity cycles persist. This makes barrier repair a formulation responsibility rather than a marketing add-on.
Structural Support Requires More Than Moisture
The outer skin layer is organized as lipid sheets interspersed with protein-rich cells. This architecture limits water escape and reduces external irritant penetration. When disrupted, mechanical integrity weakens and sensitivity increases.
Effective barrier-first formulation therefore requires ingredients that contribute to lipid organization and structural cohesion, not simply surface hydration. Supporting cholesterol balance, lamellar organization, and protein compatibility helps restore skin resilience after environmental stress, cleansing cycles, and routine exposure to irritants.


For formulators, this reframes moisturization as only one part of skin recovery. Structural lipid support and skin-compatible bioactives must work alongside humectants to deliver durable improvements in barrier integrity.
Microbiome Compatibility Is Now a Formulation Priority
The skin microbiome plays a regulatory role in immune signaling and barrier maintenance. Disruption of microbial balance can intensify dryness, irritation, and visible redness. As awareness grows, microbiome-friendly positioning has become a common product objective.
However, formulation realities complicate implementation. Preservation systems must maintain product safety, yet overly aggressive antimicrobial environments may disturb beneficial microbial populations. Ingredient combinations must also preserve pH compatibility and avoid destabilizing microbial equilibrium.
This creates a need for ingredient systems that help support microbiota balance while reinforcing barrier function — without introducing formulation complexity or preservation conflicts.
Minimalist INCI Expectations Require Multifunctional Ingredients
Ingredient-aware consumers often associate shorter INCI lists with transparency and safety. While formulation complexity is not inherently problematic, perception strongly influences product trust and purchase decisions.
Shorter ingredient decks therefore impose an efficiency requirement. Each component must serve multiple functional roles — supporting hydration, tolerance, structural integrity, and compatibility simultaneously.
Multifunctional actives provide a strategic advantage by contributing to several biological pathways within a single ingredient. This allows formulators to maintain streamlined compositions while strengthening performance credibility.
This efficiency is particularly valuable in sensitive-skin formulations, where excess components may increase irritation risk.
Marine Bioactives Offer Structural and Compatibility Advantages
Marine ecosystems produce organisms adapted to extreme environmental stress. These adaptations result in lipid-rich, antioxidant-dense compositions that align closely with skin barrier biology.
Marine-derived lipids and sterol-rich extracts are especially compatible with the extracellular matrix that maintains barrier cohesion. Their structural similarity to skin lipids allows them to integrate more effectively into lamellar architecture.
In addition to supporting lipid organization, marine bioactives often exhibit anti-inflammatory and antioxidant properties that help reduce visible irritation and environmental stress responses.
For formulators, marine-derived materials offer several advantages:
• Lipid systems compatible with barrier architecture
• Support for visible skin comfort
• Microbiome-conscious positioning
• Alignment with clean and sustainability narratives
This combination strengthens both product performance and market positioning.
Formulation Strategy in Practice: A Barrier-First Architecture
A barrier-first design approach prioritizes structural reinforcement and compatibility before layering performance enhancers. This strategy reduces irritation risk while improving resilience outcomes in sensitive and reactive skin types.
Marine OceanMist CL™ supports this architectural role as a marine-derived active designed for barrier-focused formulations. Rich in marine lipids and phytocholesterol structures, it contributes to lamellar cohesion and skin-compatible lipid organization.
By reinforcing extracellular lipid structure, formulations gain improved moisture retention and enhanced resistance to environmental stressors. The ingredient also supports microbiota balance on dry skin, enabling microbiome-friendly positioning without preservation conflicts.
Its compatibility with delicate and reactive skin makes it suitable for dermo-cosmetic moisturizers, barrier creams, and gentle daily-care formulations.
From a formulation strategy perspective, it supports:
Barrier reinforcement
Sensitive skin compatibility
Microbiome-conscious claims
Minimalist INCI efficiency
This integration allows formulators to align ingredient-aware expectations with biological performance requirements.
Aligning Clean Positioning with Functional Performance
Clean skincare positioning is increasingly defined by what formulas deliver, not only what they exclude. Ingredient-aware consumers expect evidence of tolerance, resilience, and structural support rather than simplified marketing language.
By integrating multifunctional marine bioactives into barrier-first architecture, formulators can design products that meet modern expectations without sacrificing efficacy or compatibility.
The result is skincare that supports delicate skin through structural resilience rather than superficial softness.
Conclusion: Raising the Standard for Barrier Repair
Sensitive skin formulation demands structural thinking. Barrier integrity depends on lipid organization, protein cohesion, and microbiome compatibility — not hydration alone.
Marine-derived lipid systems provide a practical pathway to reinforce these biological components while maintaining formulation simplicity and tolerance.
For brands and R&D teams developing modern clean skincare, barrier-first formulation offers a more reliable route to durable skin resilience.
Marine OceanMist CL™ FAQs
A practical starting point is 3%, since the supplier’s in vitro sensitive/atopic-skin work and in vivo microbiome study both highlight performance at that level. It is a strong use level when the goal is to support barrier repair, delicate-skin comfort, and microbiota-balancing claims in leave-on skincare. Start at 3%, then confirm the final level in your base through stability, sensory, and claims testing.
Its strongest formulation story is barrier-first care for delicate skin. Marine OceanMist CL™ is positioned to help rebuild the extracellular lamellar matrix through its phytocholesterol profile while also supporting microbiota balance on dry skin. That makes it especially relevant for products targeting dry, sensitive, atopic-prone, and very delicate skin, including gentle daily-care concepts.
The ingredient is designed to do more than reduce surface dryness. According to the supplier data, its phytocholesterol-rich microalgae profile helps support lamellar barrier rebuilding and is associated with changes in key barrier-related markers, including increased filaggrin and involucrin and reduced carbonic anhydrase 2. In practical formulation terms, that supports a more technical barrier-repair story than humectancy alone.
Yes. The supplier’s in vivo face study on very dry, sensitive skin describes Marine OceanMist CL™ as having microbiota-balancing and microbiota-nourishing properties. The data indicates increased aerobic and anaerobic microbiota levels on dry skin while preserving each volunteer’s individual microbiome composition, which is a useful foundation for microbiome-conscious positioning.
The most credible directions are supports skin barrier function, helps improve the condition of dry, sensitive skin, microbiota-balancing, and suitable for delicate skin. The supplier also presents it as non-cytotoxic and non-inflammatory in baby-skin tolerance testing, which strengthens the ingredient’s fit for gentle, clean-label, and dermo-cosmetic product concepts.
Ready to evaluate Marine OceanMist CL™?
Take the next step from insight to action. Review the data, download the PDS, and explore where Marine OceanMist CL™ may fit into your next barrier-first skincare innovation.
Forward this article to your Deveraux account managerResources
Kolb, L., & Ferrer-Bruker, S. J. (2021). Atopic dermatitis. StatPearls Publishing. https://www.ncbi.nlm.nih.gov/books/NBK448071/
Santos, R., Rodrigues, F., & Pimentel, F. B. (2023). Skin microbiome modulation and its role in cosmetic science and dermatology. International Journal of Cosmetic Science. https://pubmed.ncbi.nlm.nih.gov/41524133/
Prajapati, V. D., Maheriya, P. M., Jani, G. K., & Solanki, H. K. (2024). The emerging role of postbiotics and microbiome balance in skin health. Frontiers in Microbiology. https://pmc.ncbi.nlm.nih.gov/articles/PMC12025169/
Mourelle, M. L., Gómez, C. P., & Legido, J. L. (2025). Macro- and microalgae bioactive compounds: Applications in skin barrier repair and cosmetic science. Applied Sciences, 15(22), 11899. https://www.mdpi.com/2076-3417/15/22/11899
Happi. (2026). Clean skincare: What the new ingredient-aware consumer wants next. https://www.happi.com/exclusives/clean-skincare-what-the-new-ingredient-aware-consumer-wants-next/
Citation Note
Peer-reviewed dermatology and cosmetic science publications were selected to support barrier biology, microbiome balance, and sensitive-skin formulation principles. Industry media was included to provide market context regarding ingredient-aware consumer behavior and the growing emphasis on evidence-backed clean skincare development.








